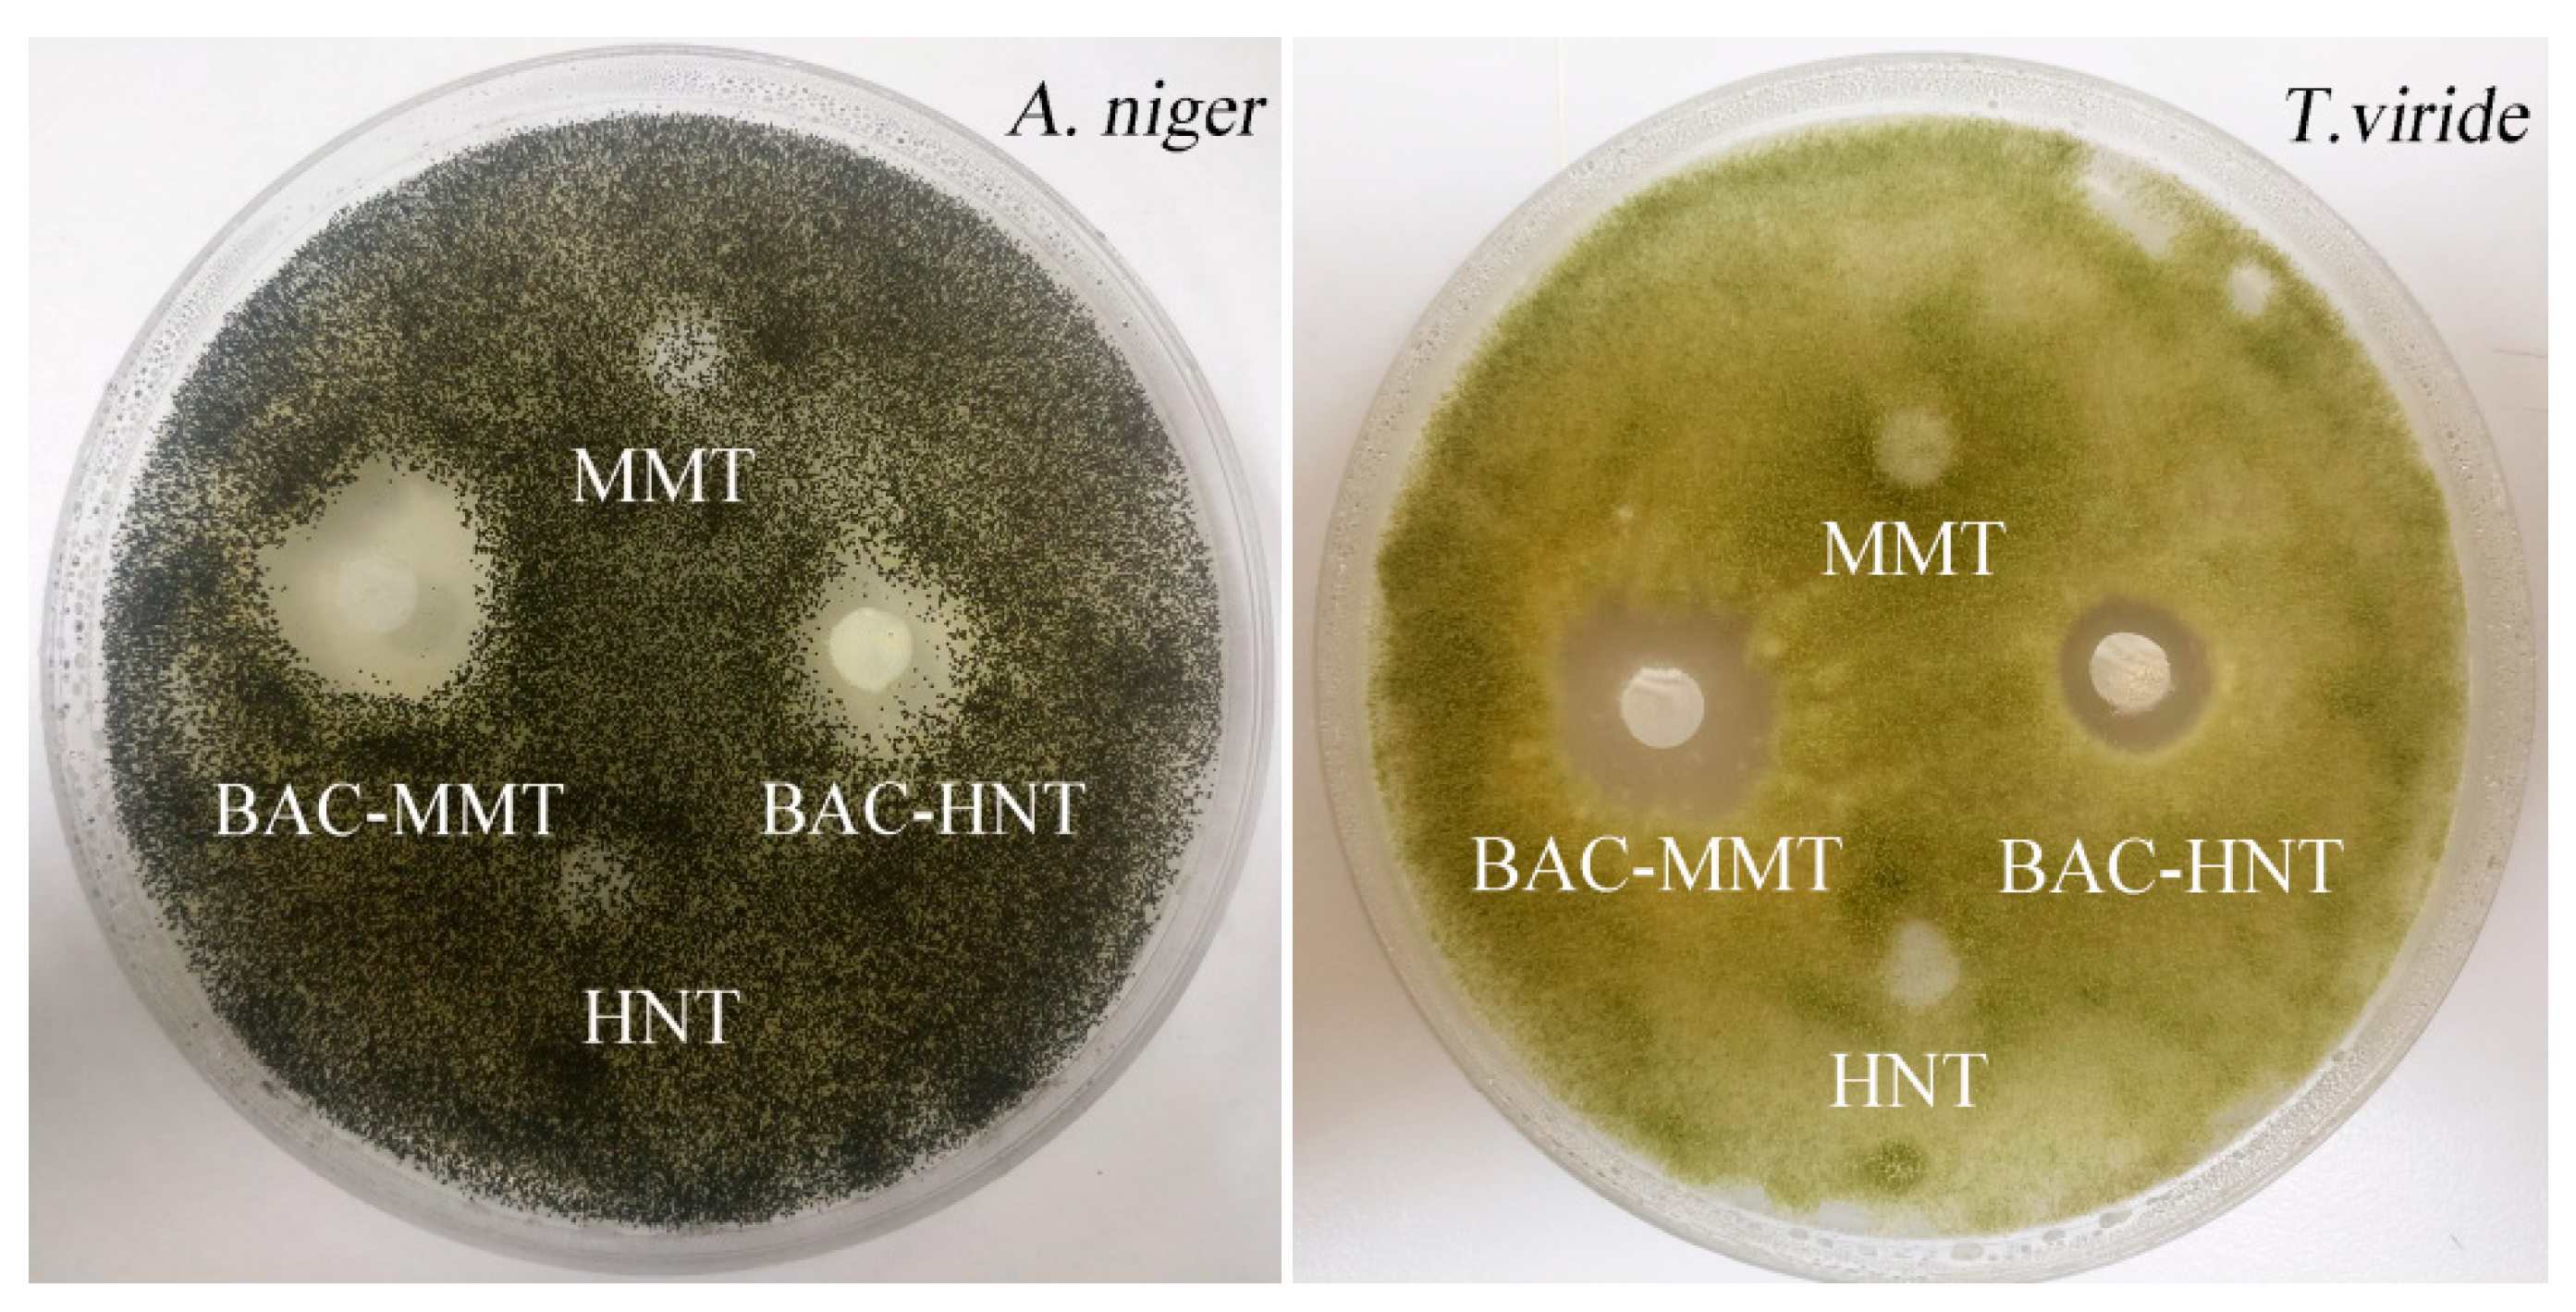
Materials 12 03780 g008

Loading and Sustained Release of Benzyl Ammonium Chloride (BAC) in Nano-Clays
Abstract
:1. Introduction
2. Materials and Methods
2.1. Materials
2.2. Preparation of BAC-Loaded HNT
2.3. Preparation of BAC-Loaded MMT
2.4. Characterization
2.4.1. Transmission Electron Microscope (TEM)
2.4.2. Fourier Transform Infrared Spectroscopy (FT-IR)
2.4.3. X-ray Diffraction (XRD)
2.4.4. Thermogravimetric Analysis (TGA)
2.4.5. Porosity Analysis
2.4.6. Accelerated Release Test
2.4.7. Inhibition Test
3. Results and Discussion
3.1. Microscopic Morphology
3.2. Thermogravimetric Analysis
3.3. FT-IR Characterization
3.4. Characterization of Crystal Structure
3.5. Analysis of Specific Surface Area and Aperture Structure
3.6. Release Profile of BAC from Nano-Clays
3.7. Inhibition Zone Test
4. Conclusions
Author Contributions
Funding
Conflicts of Interest
References
- Buffet-Bataillon, S.; Tattevin, P.; Bonnaure-Mallet, M.; Jolivet-Gougeon, A. Emergence of resistance to antibacterial agents: The role of quaternary ammonium compounds—A critical review. Int. J. Antimicrob. Agents 2012, 39, 381–389. [Google Scholar] [CrossRef] [PubMed]
- Liu, W.S.; Wang, C.H.; Sun, J.F.; Hou, G.G.; Wang, Y.P.; Qu, R.J. Synthesis, characterization and antibacterial properties of dihydroxy quaternary ammonium salts with long chain alkyl bromides. Chem. Biol. Drug Des. 2015, 85, 91–97. [Google Scholar] [CrossRef] [PubMed]
- Jiao, Y.; Niu, L.-N.; Ma, S.; Li, J.; Tay, F.R.; Chen, J.-H. Quaternary ammonium-based biomedical materials: State-of-the-art, toxicological aspects and antimicrobial resistance. Prog. Polym. Sci. 2017, 71, 53–90. [Google Scholar] [CrossRef]
- Liu, Y.; Li, M.; Qiao, M.; Ren, X.; Huang, T.S.; Buschle-Diller, G. Antibacterial membranes based on chitosan and quaternary ammonium salts modified nanocrystalline cellulose. Polym. Adv. Technol. 2017, 28, 1625–1639. [Google Scholar] [CrossRef]
- Lecoq, E.; Desbrieres, J.; Clement, F.; Leclaire, C.; Held, B. Wood protective fungicidal treatment: Quaternary ammonium molecules grafting on cellulose assisted by afterglows at atmospheric pressure. Plasma Process. Polym. 2013, 10, 150–160. [Google Scholar] [CrossRef]
- Miyauchi, T.; Mori, M.; Imamura, Y. Leaching characteristics of homologues of benzalkonium chloride from wood treated with ammoniacal copper quaternary wood preservative. J. Wood Sci. 2008, 54, 225–232. [Google Scholar] [CrossRef]
- Kamaly, N.; Yameen, B.; Wu, J.; Farokhzad, O.C. Degradable Controlled-Release Polymers and Polymeric Nanoparticles: Mechanisms of Controlling Drug Release. Chem. Rev. 2016, 116, 2602. [Google Scholar] [CrossRef]
- Aguzzi, C.; Cerezo, P.; Viseras, C.; Caramella, C. Use of clays as drug delivery systems: Possibilities and limitations. Appl. Clay Sci. 2007, 36, 22–36. [Google Scholar] [CrossRef]
- Yang, J.-H.; Lee, J.-H.; Ryu, H.-J.; Elzatahry, A.A.; Alothman, Z.A.; Choy, J.-H. Drug–clay nanohybrids as sustained delivery systems. Appl. Clay Sci. 2016, 130, 20–32. [Google Scholar] [CrossRef]
- Lvov, Y.; Abdullayev, E. Functional polymer–clay nanotube composites with sustained release of chemical agents. Prog. Polym. Sci. 2013, 38, 1690–1719. [Google Scholar] [CrossRef]
- Lvov, Y.M.; Shchukin, D.G.; Mohwald, H.; Price, R.R. Halloysite clay nanotubes for controlled release of protective agents. ACS Nano 2008, 2, 814–820. [Google Scholar] [CrossRef] [PubMed]
- Liu, H.; Wang, Z.-G.; Liu, S.-L.; Yao, X.; Chen, Y.; Shen, S.; Wu, Y.; Tian, W. Intracellular pathway of halloysite nanotubes: Potential application for antitumor drug delivery. J. Mater. Sci. 2019, 54, 693–704. [Google Scholar] [CrossRef]
- Massaro, M.; Cavallaro, G.; Colletti, C.G.; D’Azzo, G.; Guernelli, S.; Lazzara, G.; Pieraccini, S.; Riela, S. Halloysite nanotubes for efficient loading, stabilization and controlled release of insulin. J. Colloid Interface Sci. 2018, 524, 156–164. [Google Scholar] [CrossRef] [PubMed]
- Elshad, A.; Anupam, J.; Wenbo, W.; Yafei, Z.; Yuri, L. Enlargement of halloysite clay nanotube lumen by selective etching of aluminum oxide. Acs Nano 2012, 6, 7216–7226. [Google Scholar]
- Xiaoying, W.; Yumin, D.; Jiwen, L. Biopolymer/montmorillonite nanocomposite: Preparation, drug-controlled release property and cytotoxicity. Nanotechnology 2008, 19, 1–7. [Google Scholar]
- Jayrajsinh, S.; Shankar, G.; Agrawal, Y.K.; Bakre, L. Montmorillonite nanoclay as a multifaceted drug-delivery carrier: A review. J. Drug Deliv. Sci. Technol. 2017, 39, 200–209. [Google Scholar] [CrossRef]
- Zheng, J.; Luan, L.; Wang, H.; Xi, L.; Yao, K. Study on ibuprofen/montmorillonite intercalation composites as drug release system. Appl. Clay Sci. 2007, 36, 297–301. [Google Scholar] [CrossRef]
- Harada, M.; Miyamoto, T.; Ochi, M. Clay dispersibility and mechanical property of the epoxy/clay nanocomposites prepared by different treatment methods. J. Polym. Sci. Part B Polym. Phys. 2009, 47, 1753–1761. [Google Scholar] [CrossRef]
- Biemer, J.J. Antimicrobial susceptibility testing by the Kirby-Bauer disc diffusion method. Ann. Clin. Lab. Sci. 1973, 3, 135–140. [Google Scholar]
- Gaaz, T.; Sulong, A.; Kadhum, A.; Nassir, M.; Al-Amiery, A. Impact of sulfuric acid treatment of halloysite on physico-chemic property modification. Materials 2016, 9, 620. [Google Scholar] [CrossRef]
- Li, Y.; Zhang, Y.; Zhang, Y.; Sun, J.; Wang, Z. Thermal behavior analysis of halloysite–dimethylsulfoxide intercalation complex. J. Therm. Anal. Calorim. 2017, 129, 985–990. [Google Scholar] [CrossRef]
- Liu, M.; Jia, Z.; Jia, D.; Zhou, C. Recent advance in research on halloysite nanotubes-polymer nanocomposite. Prog. Polym. Sci. 2014, 39, 1498–1525. [Google Scholar] [CrossRef]
- Soares, V.L.; Nascimento, R.S.V.; Menezes, V.J.; Batista, L. TG characterization of organically modified montmorillonite. J. Therm. Anal. Calorim. 2004, 75, 671–676. [Google Scholar] [CrossRef]
- Raji, M.; Mekhzoum, M.E.M.; el Kacem Qaiss, A.; Bouhfid, R. Nanoclay modification and functionalization for nanocomposites development: Effect on the structural, morphological, mechanical and rheological properties. In Nanoclay Reinforced Polymer Composites; Springer: Berlin, Germany, 2016; pp. 1–34. [Google Scholar]
- Mahesh, K.V.; Murthy, H.N.; Kumaraswamy, B.; Raghavendra, N.; Sridhar, R.; Krishna, M.; Pattar, N.; Pal, R.; Sherigara, B. Synthesis and characterization of organomodified Na-MMT using cation and anion surfactants. Front. Chem. China 2011, 6, 153–158. [Google Scholar] [CrossRef]
- Zhou, N.; Qiu, P.; Wang, K.; Fu, H.; Cui, D. Shape-controllable synthesis of hydrophilic NaLuF4:Yb,Er nanocrystals by a surfactant-assistant two-phase system. Nanoscale Res. Lett. 2013, 8, 518. [Google Scholar] [CrossRef] [PubMed]
- Khalil, R.K.S. Selective removal and inactivation of bacteria by nanoparticle composites prepared by surface modification of montmorillonite with quaternary ammonium compounds. World J. Microbiol. Biotechnol. 2013, 29, 1839–1850. [Google Scholar] [CrossRef]
- Horváth, E.; Kristóf, J.; Kurdi, R.; Makó, É.; Khunová, V. Study of urea intercalation into halloysite by thermoanalytical and spectroscopic techniques. J. Therm. Anal. Calorim. 2011, 105, 53–59. [Google Scholar] [CrossRef]
- Flores, F.M.; Loveira, E.L.; Yarza, F.; Candal, R.; Sánchez, R.M.T. Benzalkonium Chloride Surface Adsorption and Release by Two Montmorillonites and Their Modified Organomontmorillonites. Water Air Soil Pollut. 2017, 228, 42. [Google Scholar] [CrossRef]
- Kuila, U.; Prasad, M. Specific surface area and pore-size distribution in clays and shales. Geophys. Prospect. 2013, 61, 341–362. [Google Scholar] [CrossRef]
- Qin, W.; Zhang, J.; Yue, Z.; Wang, A. Adsorption and release of ofloxacin from acid- and heat-treated halloysite. Colloids Surf. B Biointerfaces 2014, 113, 51–58. [Google Scholar]

| Benzyl Ammonium Chloride (BAC) | Halloysite (HNT) | Montmorillonite (MMT) | |||
|---|---|---|---|---|---|
| Wavenumber (cm−1) | Assignment | Wavenumber (cm−1) | Assignment | Wavenumber (cm−1) | Assignment |
| 2900 | –CH2– asymmetrical stretching vibration | 3695 and 3619 | inner Al–OH stretching vibration | 3625 | Al–OH stretching vibration |
| 2850 | symmetrical stretching vibration of –CH2– | 1031 | Si–O–Si stretching vibration | 3430 | H–O–H stretching vibration |
| 1471 | C = C stretching vibration | 912 | O-H bending vibrations | 1637 | H–O–H bending vibration |
| 740 | aromatic rings out-of-plane bending vibration | 747 and 797 | Al–OH vibrations of the surface hydroxyl groups | 1039 | Si–O–Si stretching vibration |
| – | – | 534 | Al–O–Si bending vibration | 522 | Si–O–Si bending vibration |
| – | – | 468 | Si–O–Si bending vibration | 463 | Al–O bending vibration |
| Sample | Pecific Surface Area/(m2·g−1) | Total Pore Volume/(cm3·g−1) | Average Pore Size/(nm) |
|---|---|---|---|
| HNT | 43.97 | 0.138 | 15.58 |
| Acid-HNT | 50.22 | 0.290 | 25.03 |
| BAC-HNT | 28.98 | 0.150 | 20.07 |
| MMT | 57.51 | 0.098 | 6.80 |
| BAC-MMT | 12.24 | 0.047 | 15.56 |
© 2019 by the authors. Licensee MDPI, Basel, Switzerland. This article is an open access article distributed under the terms and conditions of the Creative Commons Attribution (CC BY) license (http://creativecommons.org/licenses/by/4.0/).
Share and Cite
Yue, X.; Zhang, R.; Li, H.; Su, M.; Jin, X.; Qin, D. Loading and Sustained Release of Benzyl Ammonium Chloride (BAC) in Nano-Clays. Materials 2019, 12, 3780. https://doi.org/10.3390/ma12223780
Yue X, Zhang R, Li H, Su M, Jin X, Qin D. Loading and Sustained Release of Benzyl Ammonium Chloride (BAC) in Nano-Clays. Materials. 2019; 12(22):3780. https://doi.org/10.3390/ma12223780
Chicago/Turabian StyleYue, Xianfeng, Rong Zhang, Huairui Li, Minglei Su, Xiaobei Jin, and Daochun Qin. 2019. "Loading and Sustained Release of Benzyl Ammonium Chloride (BAC) in Nano-Clays" Materials 12, no. 22: 3780. https://doi.org/10.3390/ma12223780
APA StyleYue, X., Zhang, R., Li, H., Su, M., Jin, X., & Qin, D. (2019). Loading and Sustained Release of Benzyl Ammonium Chloride (BAC) in Nano-Clays. Materials, 12(22), 3780. https://doi.org/10.3390/ma12223780




